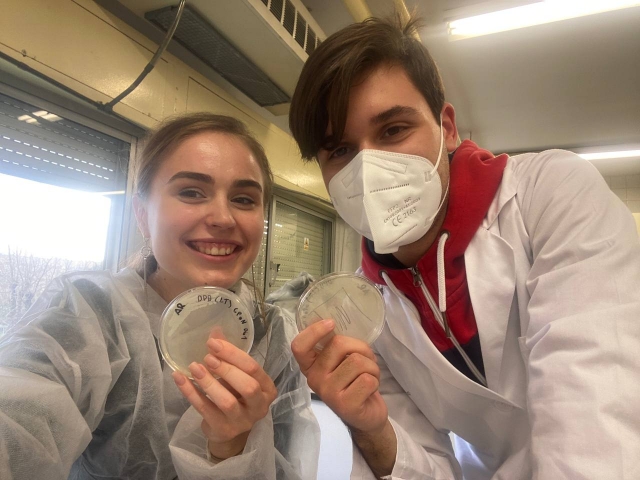
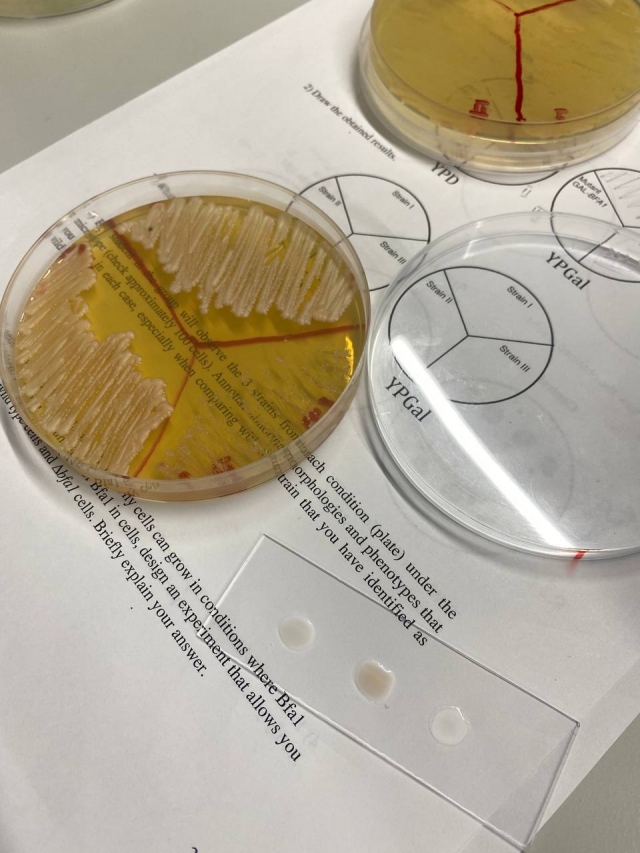

Навчання за обміном, мрії що втілюються у реальність
Normal
0
21
false
false
false
UK
X-NONE
X-NONE
Навчання за програмою обміну в Університеті Севілья Universidad de Sevilla (Іспанія) : враження студентки Тхорик Любові.

ЕРАЗМУС+ – це Програма міжнародної співпраці Європейського Союзу з іншими країнами світу у сфері освіти, молоді та спорту.
Програма підтримує можливості навчальної та академічної мобільності в освіті та для молоді, проєкти та партнерства, розвиток стратегій і співпраці.

Перший крок для успішного отримання програми обміну:
• Цікавий та змістовний мотиваційний лист
• Коректно сформоване резюме що містить ключові моменти вашого життя
• Академічний рейтинг навчання 90+ балів
• Рівень володіння англійською мовою мінімально на В1

Програма мобільності надає неймовірні можливості навчання в европейських країнах, теоретичний та практичний досвід в сучасних лабораторіях, нові знайомства й друзі, можливість дізнатися культуру та звичаї іншої країни.
Серед програм для бакалаврів приймаючим університетом Universidad de Sevilla було запропоновано англомовну програму Erasmus +, терміном на два семестри 2022-2023 року до якої залюбки долучилася . Після отримання позитивного результату участі у конкурсі, я із задоволенням почала готуватися до мобільності.

Протягом семестрів, навчання відбувалося в цікавому колективі іспаномовних студентів, котрі показували щиру відкритість в спілкуванні та активну зацікавленість у навчанні під час лекцій та практичних занять, що давало додаткові стимули для роботи разом.

Разом з тим було отримано багато позитивних вражень від знайомства зі студентами багатьох куточків світу, зокрема Франції, Італії та США.

Найбільше мені сподобалися лабораторні заняття з таких дисциплін, як генетика, мікробіологія, фізіологія овочів та екологія. Також ми мали виїзні практичні роботи та екскурсії.

Навчальні дисципліни, були цікавими та мали міждисциплінарне наповнення, що чудово доповнили мої набуті теоретичні та практичні знання та вміння за спеціальністю “Агрономія”.




Це нагода дізнатися про біорізноманіття іншої країни, ландшафт та рельєф, економічні та соціальні складові сільського господарства в цілому.

На період канікул, у вільний час, з великим захопленням у колі друзів ми подорожували та отримували найприємніші враження.

За отриманий досвід та глибокі знання отримані в ході мобільності хотілось би виразити найщирішу подяку усім, хто відповідав за організацію навчання, деканату Агробіологічного факультету, керівництву та співробітникам міжнародного відділу НУБІП Укаїни, проректору з науково-педагогічної роботи, міжнародної діяльності та розвитку Вадиму Ткачуку.
Кожен студент, який планує дану мобільність може бути впевнений, що він отримає найкращий досвід та проведе дивовижний час в дуже дружньому колективі протягом навчання!

Рекомендую усім студентам брати участь у мобільності.
ЕРАЗМУС+ може відкрити двері для нових освітніх можливостей, щоб отримати нові навички, які підготують до майбутньої кар’єри та принесуть чудовий досвід. Знання, отримані за кордоном, стануть у пригоді не лише як власний досвід, а й як здобуток для університету.
Інтеграція в європейське та освітньо наукове середовище сприяє підвищенню практичних та теоретичних навичок студентства.
Любов Тхорик,
голова сенату студентської організації агробіологічного факультету